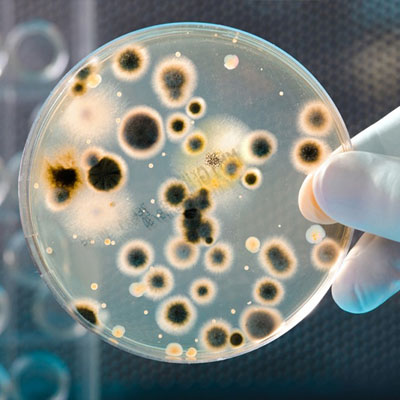

___
Mold Research
"Research on mold and health effects is ongoing." - EPA
Call (818) 964-1533
Schedule Inspection
What is Mold?
Molds are a natural part of the environment as they are an abundant life form that belong to the Fungi kingdom.
Outdoors, they play a vital role in breaking down dead organic matter such as fallen leaves, or other plant matter and recycle nutrients back into the earth.
However, mold growth should be avoided indoors as they have the potential to cause both property damage and health problems.

Common molds found indoors may include Cladosporium, Penicillium, Aspergillus, Alternaria, Stachybotrys, Chaetomium and Ulocladium.
Can Molds Cause Health Problems?
Important: Licensed medical professionals should be consulted for any health related questions or concerns.
Immune-compromised people and people with chronic lung disease may get infections in their lungs from mold. For people who are sensitive to molds exposure to molds can lead to symptoms such as stuffy nose, wheezing, and red or itchy eyes, or skin.
Severe reactions, such as fever or shortness of breath, may occur among workers exposed to large amounts of molds in occupational settings, such as farmers working around moldy hay."
According to the EPA: "Inhaling or touching mold or mold spores may cause allergic reactions in sensitive individuals. Allergic responses include hay fever-type symptoms, such as sneezing, runny nose, red eyes, and skin rash (dermatitis). Allergic reactions to mold are common. They can be immediate or delayed.
Molds can also cause asthma attacks in people with asthma who are allergic to mold. In addition, mold exposure can irritate the eyes, skin, nose, throat, and lungs of both mold-allergic and non-allergic people."
Learn about our Mold Testing and Inspection Services:
Our Services Call (818) 964-1533Schedule Inspection
What causes mold to grow indoors?
Molds require moisture and a food source in order to grow.
Mold spores are microscopic seedlike structures. Spores may spread from the outdoor air into the indoor environment and given the right conditions, they can reproduce.
Growth may begin 24 to 48 hours after the spores land on wet surfaces.
What are mycotoxins?
The CDC explains:
"Certain molds are toxigenic, meaning they can produce toxins (mycotoxins).
However, the molds themselves are not toxic or poisonous.
Molds that produce mycotoxins, like Stachybotrys chartarum, should be considered the same as other molds that can grow in your house or workplace.
Any mold growing in buildings indicates a problem with water or moisture and should be immediately addressed."
What is Stachybotrys chartarum, often known as Black Mold?
According to the CDC: "Stachybotrys chartarum is a greenish-black mold.
It can grow on material with a high cellulose content, such as fiberboard, gypsum board, and paper.
Growth occurs when there is moisture from water damage, water leaks, condensation, water infiltration, or flooding.
Constant moisture is required for its growth.
All molds should be treated the same with respect to potential health risks and removal."
What are hydrophilic molds?
Hydrophilic molds, often called "water-loving" or tertiary colonizers, are fungi that require high levels of moisture — specifically a water activity of 0.90 or higher—to grow.
These molds are typically the last to appear during a water damage event because they need materials to be continuously wet or saturated rather than just damp.
High Water Requirement: They thrive on materials that have experienced severe leaks, floods, or chronic condensation. Stachybotrys and Chaetomium are among hydrophilic molds.
Aerosolization: Many hydrophilic molds have sticky spores that do not easily become airborne unless the material dries out or is physically disturbed.
What are xerophilic molds?
Xerophilic molds (literally "dry-loving") are fungi that can grow in environments with little available water.
While hydrophilic molds need a lot of water to grow, xerophilic molds can thrive on just high humidity.
They are defined by their ability to grow at a water activity of 0.85 or below—and some extreme species can even survive down to 0.65.
Humidity Feeders: Xerophilic molds can pull enough moisture directly from the air if the relative humidity (RH) is consistently above 60-70%.
Primary Colonizers: They are often the first molds to appear when a room gets stuffy or damp, often paving the way for other molds later. Examples include Aspergillus and Penicillium species.
What are Hyphal fragments?
Hyphal fragments are basically the "broken-off branches" of a mold colony. If you think of mold as a plant, the spores are the "seeds," and the hyphae are the "roots and stems." When a colony is disturbed, dries out, or grows aggressively, these root-like structures can break apart into smaller pieces called fragments.
Indicator of Active Growth: Finding hyphal fragments on a lab report (especially an air sample) can point to a higher probablility of local mold colonization than finding spores alone. Spores can float in from an open window, but hyphal fragments are heavier and don't travel as far. Finding them in the air may indicate that an active mold colony exists nearby.
Disclaimer: The information provided on this page and this web site is for educational purposes only. Moisture levels, mold species, and building conditions vary significantly; therefore, this data should not be used as a substitute for a professional mold inspection or formal lab analysis. Always consult with qualified and licensed professionals before making structural repairs or health-related decisions. Licensed medical professionals should be consulted for any health related questions or concerns.
OUR PROCESS

We start with performing a visual inspection of the property, focusing on areas where there may be water damage, moisture issues or suspected mold growth.

With the help of specialized tools we may take environmental readings such as moisture or humidity levels in order to identify any potential issues.

Surface and air samples may be recommended depending on the inspection findings or customer concerns. Such samples are sent to a lab that specializes in identifying and analyzing mold spores.

Once all of the data is collected, we provide a report of our findings. If a mold growth problem is identified, a remediation protocol is outlined.
What happens during a Mold Inspection?
What Technology is Used?
CONTACT US
Please let us know of any mold and indoor air quality questions and concerns. Contact us to schedule an inspection:
Call (818) 964-1533 Schedule InspectionCustomer Reviews
The 'Test Only' Advantage
Frequently Asked Questions
Happily serving our customers in Granada Hills, Porter Ranch, Northridge, North Hills, Reseda, Canoga Park, Woodland Hills, Encino, Simi Valley, Moorpark, Thousand Oaks, Calabasas, Agoura Hills, Malibu, Camarillo, Oxnard, Ventura, Newhall, Valencia, Canyon Country, Santa Monica, Marina Del Ray, Glendale, Pasadena, Alta Dena, Burbank, Studio City, Brentwood, Beverly Hills, Hollywood, West Hollywood, North Hollywood and the San Fernando Valley and the Greater Los Angeles Area.
Indoor Air Quality (IAQ)
~ Water Damage Assessments
~ AIHA (American Industrial Hygiene Association) Accredited Lab Testing
~ Presale Home Inspections
~ Post Remediation Clearance Testing
~ Air & Surface Sampling
~ Mold Remediation Protocols
~ Findings & Recommendations Reports
~ Environmental Testing
~ Mold Inspection Los Angeles
~ Certified Mold Testing Services
Find us on nextdoor:






MICRO Certified Mold Inspector CMI # 86294
InterNACHI (International Association of Certified Home Inspectors) Certified Mold Inspector
Member # NACHI25081826 Certificate # 1755634505
IAC2 Certified, IAC2 Mold Certified (International Association of Certified Indoor Air Consultants)
Certification ID: IAC2-95070


